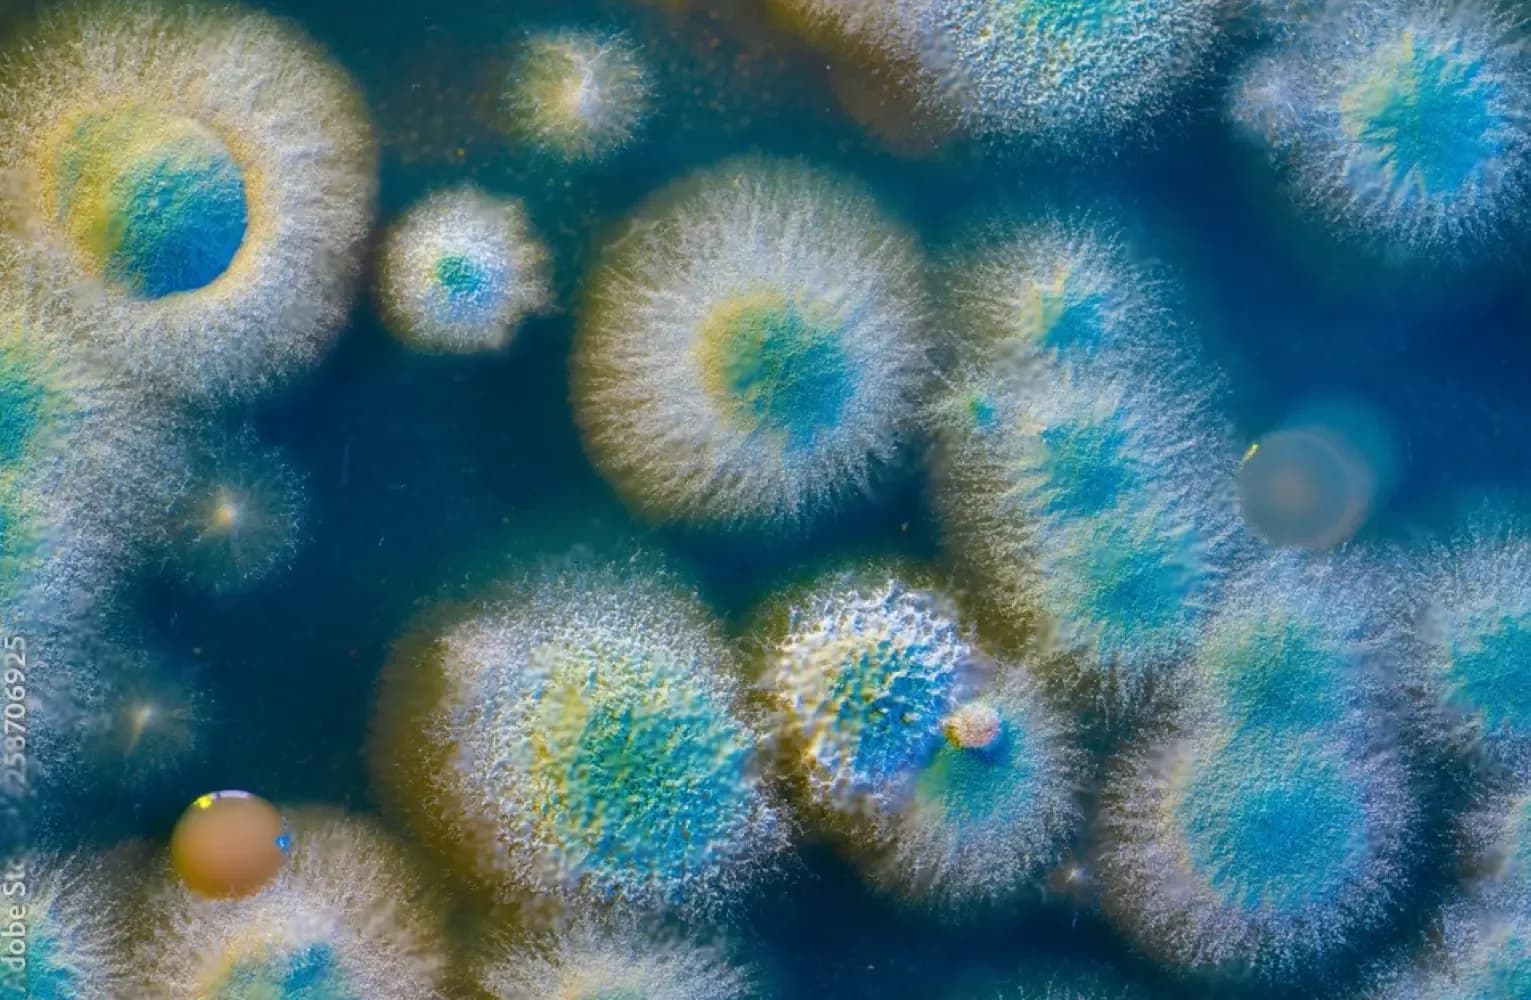
preview

Nấm tai ngoài là gì?

PGS.TS.TTƯT Lê Lương Đống
Nấm tai ngoài là một bệnh lý nhiễm trùng phổ biến ảnh hưởng đến phần ngoài của ống tai, gây ra bởi sự phát triển quá mức của nấm và vi khuẩn. Bệnh lý này không chỉ gây khó chịu mà còn có thể dẫn đến các biến chứng nghiêm trọng nếu không được điều trị kịp thời. Hiểu biết về nấm tai ngoài, bao gồm nguyên nhân, triệu chứng, phương pháp chẩn đoán và điều trị, là rất quan trọng để bảo vệ sức khỏe tai của bạn.

Bài viết này sẽ cung cấp thông tin chi tiết về nấm tai ngoài, giúp bạn nhận biết các dấu hiệu bệnh lý, hiểu rõ các yếu tố nguy cơ và áp dụng các biện pháp phòng ngừa hiệu quả.
1. Nấm tai ngoài là gì ?
Nấm tai ngoài, hay còn gọi là viêm tai ngoài do nấm (otomycosis), là một bệnh lý nhiễm trùng ảnh hưởng đến ống tai ngoài. Bệnh này được gây ra bởi sự phát triển quá mức của nấm trong ống tai. Các loại nấm phổ biến gây bệnh bao gồm Aspergillus và Candida.

Nấm tai ngoài thường xuất hiện ở những người có điều kiện ẩm ướt trong tai do bơi lội, sử dụng tai nghe hoặc nút tai trong thời gian dài, hoặc vệ sinh tai không đúng cách. Bệnh cũng phổ biến hơn ở những người có hệ miễn dịch suy yếu hoặc đã sử dụng thuốc kháng sinh kéo dài.
Tham khảo:
2. Nguyên nhân gây nấm tai ngoài
Nấm tai ngoài là một bệnh lý do sự phát triển quá mức của nấm trong ống tai ngoài. Để hiểu rõ về nguyên nhân gây bệnh, chúng ta cần xem xét các yếu tố góp phần vào sự phát triển và lây nhiễm của nấm trong tai.
2.1. Vi khuẩn và nấm gây bệnh
2.1.1. Các loại nấm phổ biến gây nấm tai ngoài
- Aspergillus: Đây là loại nấm phổ biến nhất gây ra nấm tai ngoài. Aspergillus có khả năng phát triển mạnh trong môi trường ẩm ướt và tối, chẳng hạn như ống tai ngoài.

- Candida: Loại nấm này cũng có thể gây nấm tai ngoài, mặc dù ít phổ biến hơn so với Aspergillus. Candida thường xuất hiện ở những người có hệ miễn dịch suy yếu hoặc đã sử dụng thuốc kháng sinh kéo dài.
2.1.2. Cách vi khuẩn và nấm xâm nhập
-
Môi trường ẩm ướt: Nấm phát triển tốt trong môi trường ẩm ướt. Khi ống tai ngoài giữ ẩm trong thời gian dài do các yếu tố như bơi lội, đổ mồ hôi hoặc vệ sinh tai không đúng cách, nấm có cơ hội phát triển và gây nhiễm trùng.
-
Vi khuẩn: Mặc dù chủ yếu là nấm gây bệnh, nhưng sự hiện diện của vi khuẩn cũng có thể làm tình trạng viêm nhiễm phức tạp hơn, tạo điều kiện cho nấm phát triển mạnh hơn.
2.2. Yếu tố nguy cơ
2.2.1. Sử dụng tai nghe hoặc nút tai trong thời gian dài
- Giữ ẩm: Tai nghe hoặc nút tai sử dụng trong thời gian dài có thể giữ ẩm trong ống tai, tạo môi trường thuận lợi cho nấm phát triển.

- Cản trở lưu thông không khí: Tai nghe và nút tai ngăn cản lưu thông không khí trong ống tai, làm tăng độ ẩm và nhiệt độ, hai yếu tố quan trọng giúp nấm phát triển.
2.2.2. Tiếp xúc thường xuyên với nước
-
Bơi lội: Người thường xuyên bơi lội, đặc biệt là trong nước không sạch, có nguy cơ cao mắc nấm tai ngoài do ống tai luôn trong trạng thái ẩm ướt.
-
Môi trường ẩm ướt: Sống hoặc làm việc trong môi trường ẩm ướt cũng tăng nguy cơ mắc bệnh.
2.2.3. Hệ miễn dịch suy yếu hoặc sử dụng thuốc kháng sinh kéo dài
- Hệ miễn dịch suy yếu: Những người có hệ miễn dịch suy yếu do bệnh tật, căng thẳng hoặc dinh dưỡng kém dễ bị nhiễm nấm hơn do cơ thể không đủ khả năng chống lại sự xâm nhập của nấm.

- Sử dụng thuốc kháng sinh kéo dài: Kháng sinh có thể tiêu diệt cả vi khuẩn có lợi trong cơ thể, làm mất cân bằng hệ vi sinh vật trong tai và tạo điều kiện cho nấm phát triển. Kháng sinh cũng có thể làm suy yếu hệ miễn dịch, khiến cơ thể khó chống lại nhiễm trùng nấm.
Việc hiểu rõ nguyên nhân gây nấm tai ngoài giúp chúng ta có cái nhìn toàn diện về bệnh lý này và áp dụng các biện pháp phòng ngừa hiệu quả. Các yếu tố nguy cơ như môi trường ẩm ướt, sử dụng tai nghe hoặc nút tai trong thời gian dài, và hệ miễn dịch suy yếu đều có thể được kiểm soát thông qua việc thay đổi thói quen sinh hoạt và duy trì vệ sinh cá nhân tốt. Đồng thời, việc nhận biết sớm các dấu hiệu của nấm tai ngoài sẽ giúp chúng ta tìm kiếm điều trị kịp thời, ngăn ngừa các biến chứng nghiêm trọng và bảo vệ sức khỏe tai.
Tham khảo:
3. Triệu chứng của nấm tai ngoài
Việc nhận biết các triệu chứng của nấm tai ngoài là rất quan trọng để có thể phát hiện sớm và điều trị kịp thời. Dưới đây là phân tích chi tiết về các triệu chứng phổ biến của nấm tai ngoài:
3.1. Ngứa tai
Ngứa tai là triệu chứng phổ biến nhất của nấm tai ngoài. Người bệnh thường cảm thấy ngứa liên tục trong tai, cảm giác này có thể từ nhẹ đến rất khó chịu.
Ngứa tai do nấm gây ra là kết quả của phản ứng viêm do sự phát triển của nấm trong ống tai. Nấm kích thích các tế bào niêm mạc tai, gây ra cảm giác ngứa.

Người bệnh có xu hướng gãi hoặc chọc ngoáy vào tai để giảm ngứa, điều này có thể gây tổn thương niêm mạc tai, làm tình trạng viêm nhiễm trở nên nặng hơn.
3.2. Đau tai
3.2.1. Mức độ và loại đau
- Đau nhẹ đến nặng: Cảm giác đau có thể dao động từ nhẹ đến dữ dội, thậm chí là đau nhói.

- Đau khi chạm vào tai: Đôi khi chỉ cần chạm nhẹ vào tai cũng có thể gây ra cảm giác đau đớn.
3.2.2. Nguyên nhân gây đau
-
Viêm và sưng: Đau tai là do viêm và sưng trong ống tai gây áp lực lên các dây thần kinh.
-
Tổn thương niêm mạc tai: Việc gãi hoặc chọc ngoáy vào tai có thể gây tổn thương niêm mạc, dẫn đến đau.
3.3. Cảm giác đầy tai hoặc có vật lạ trong tai
-
Cảm giác đầy tai: Người bệnh thường cảm thấy tai bị nghẽn hoặc đầy, giống như có vật lạ bên trong.
-
Nguyên nhân gây ra: Cảm giác này thường do sự tích tụ của dịch nhầy hoặc mủ trong ống tai gây ra bởi viêm nhiễm.
3.4. Chảy mủ từ tai
3.4.1. Dịch mủ
-
Màu sắc và mùi: Dịch mủ có thể có màu trắng, vàng hoặc đen, và thường có mùi hôi khó chịu.
-
Lượng dịch: Lượng dịch chảy ra có thể thay đổi từ ít đến nhiều, tùy thuộc vào mức độ viêm nhiễm.

3.4.2. Nguyên nhân xuất hiện dịch mủ
-
Phản ứng viêm: Chảy mủ là kết quả của phản ứng viêm do nhiễm nấm. Các tế bào bạch cầu và vi khuẩn chết cùng với dịch viêm tạo thành mủ.
-
Nhiễm trùng thứ cấp: Viêm nhiễm nặng có thể dẫn đến nhiễm trùng thứ cấp do vi khuẩn, làm tình trạng chảy mủ trở nên nghiêm trọng hơn.
3.5. Giảm thính lực tạm thời
3.5.1. Nguyên nhân
-
Tắc nghẽn ống tai: Sự tích tụ dịch, mủ và các mảnh vụn trong ống tai có thể làm tắc nghẽn ống tai, gây giảm thính lực tạm thời.
-
Viêm và sưng: Viêm và sưng trong ống tai gây áp lực lên màng nhĩ, làm giảm khả năng rung động của màng nhĩ, dẫn đến giảm thính lực.
3.5.2. Tác động của giảm thính lực
-
Ảnh hưởng đến giao tiếp: Giảm thính lực làm người bệnh khó khăn trong việc giao tiếp, nghe và hiểu người khác nói.
-
Ảnh hưởng đến công việc và học tập: Người bệnh có thể gặp khó khăn trong công việc và học tập do khả năng nghe kém.
Nhận biết sớm các triệu chứng của nấm tai ngoài là bước quan trọng trong việc phát hiện và điều trị bệnh kịp thời. Các triệu chứng như ngứa tai, đau tai, cảm giác đầy tai, chảy mủ từ tai và giảm thính lực tạm thời không chỉ gây khó chịu mà còn ảnh hưởng đến chất lượng cuộc sống của người bệnh. Hiểu rõ về các triệu chứng này giúp người bệnh và người chăm sóc có thể tìm kiếm sự tư vấn và điều trị từ các chuyên gia y tế một cách nhanh chóng, ngăn ngừa các biến chứng nghiêm trọng và bảo vệ sức khỏe tai.
Tham khảo:
4. Phòng ngừa nấm tai ngoài
Việc phòng ngừa nấm tai ngoài là rất quan trọng để giảm nguy cơ nhiễm trùng và bảo vệ sức khỏe tai. Dưới đây là phân tích chi tiết về các biện pháp phòng ngừa hiệu quả:
4.1. Vệ sinh tai đúng cách
-
Sử dụng khăn sạch: Khi vệ sinh tai, hãy sử dụng khăn mềm và sạch để lau vùng ngoài tai. Tránh dùng vật cứng hoặc nhọn để ngoáy tai vì có thể gây tổn thương niêm mạc tai và tạo điều kiện cho nấm xâm nhập.
-
Rửa tai bằng nước muối sinh lý: Nước muối sinh lý có tác dụng làm sạch nhẹ nhàng và giữ ẩm cho tai, giúp ngăn ngừa sự phát triển của nấm.
-
Tránh ngoáy tai quá sâu: Không nên đưa ngón tay, tăm bông hoặc các vật khác vào sâu trong ống tai vì dễ gây trầy xước và tạo môi trường thuận lợi cho nấm phát triển.

-
Tránh sử dụng tăm bông: Sử dụng tăm bông để làm sạch tai có thể đẩy ráy tai sâu hơn vào trong ống tai, gây tắc nghẽn và dễ bị nhiễm trùng.
-
Không dùng nước quá nóng hoặc quá lạnh: Nước quá nóng hoặc quá lạnh có thể gây kích ứng da và niêm mạc tai, làm tăng nguy cơ nhiễm trùng.
4.2. Tránh môi trường ẩm ướt
-
Nút tai chống nước: Sử dụng nút tai chống nước khi bơi để ngăn nước vào tai, giữ cho ống tai khô ráo và tránh môi trường ẩm ướt tạo điều kiện cho nấm phát triển.
-
Lựa chọn nút tai phù hợp: Chọn loại nút tai vừa vặn, không gây khó chịu và đảm bảo hiệu quả chống nước.

-
Lau khô tai sau khi tắm hoặc bơi: Sau khi tiếp xúc với nước, hãy dùng khăn mềm lau khô tai kỹ càng. Đặc biệt chú ý lau khô vùng sau tai và vành tai.
-
Sử dụng máy sấy tóc: Có thể sử dụng máy sấy tóc ở chế độ mát hoặc ấm nhẹ để làm khô tai, giữ tai luôn khô ráo và thoáng mát.
4.3. Duy trì sức khỏe tổng quát
-
Chế độ ăn uống lành mạnh: Ăn uống đầy đủ các nhóm thực phẩm, đặc biệt là rau xanh, trái cây, protein, và các loại hạt để cung cấp đầy đủ dinh dưỡng, tăng cường sức đề kháng.
-
Vận động thường xuyên: Tập thể dục đều đặn giúp cải thiện sức khỏe tổng quát và tăng cường hệ miễn dịch.

-
Giấc ngủ đủ: Đảm bảo ngủ đủ giấc mỗi đêm để cơ thể có thời gian phục hồi và tăng cường sức đề kháng.
-
Hạn chế kháng sinh: Chỉ sử dụng thuốc kháng sinh khi có chỉ định của bác sĩ để tránh tình trạng kháng thuốc và mất cân bằng hệ vi sinh vật tự nhiên trong cơ thể.
-
Tham khảo ý kiến bác sĩ: Khi cần sử dụng thuốc kháng sinh, hãy tuân thủ đúng liều lượng và thời gian sử dụng theo hướng dẫn của bác sĩ.
Phòng ngừa nấm tai ngoài là một quá trình liên tục đòi hỏi sự chú ý đến vệ sinh cá nhân và các yếu tố môi trường xung quanh. Bằng cách duy trì vệ sinh tai đúng cách, tránh môi trường ẩm ướt và giữ tai khô ráo sau khi tiếp xúc với nước, cũng như tăng cường sức khỏe tổng quát và hạn chế sử dụng thuốc kháng sinh không cần thiết, chúng ta có thể giảm nguy cơ nhiễm nấm tai ngoài.
Tham khảo:
5. Tổng kết
Nấm tai ngoài là một bệnh lý nhiễm trùng phổ biến ảnh hưởng đến ống tai ngoài, do sự phát triển quá mức của các loại nấm như Aspergillus và Candida. Các triệu chứng thường gặp bao gồm ngứa tai, đau tai, cảm giác đầy tai hoặc có vật lạ trong tai, chảy mủ từ tai và giảm thính lực tạm thời. Nguyên nhân gây bệnh chủ yếu là do môi trường ẩm ướt, sử dụng tai nghe hoặc nút tai trong thời gian dài, và hệ miễn dịch suy yếu.

Hiểu biết về nấm tai ngoài và các biện pháp phòng ngừa, điều trị đúng cách là rất quan trọng để bảo vệ sức khỏe tai và ngăn ngừa các biến chứng nghiêm trọng. Bằng cách nhận biết sớm các dấu hiệu của nấm tai ngoài và tìm kiếm sự tư vấn từ các chuyên gia y tế, chúng ta có thể điều trị bệnh kịp thời, duy trì thính lực tốt và cải thiện chất lượng cuộc sống.
Chú ý: Số hotline viemtaigiua.vn (0843.311.348) luôn có bác sĩ chuyên khoa tai mũi họng trực để tư vấn cho cha mẹ về tình hình bệnh của con em mình. Hãy liên hệ ngay để được tư vấn sớm nhất nhé!
6. Tham khảo
- Phương pháp điều trị viêm tai giữa
- Quan điểm mới về cơ chế bệnh sinh của viêm tai giữa cấp và các biến chứng của nó
- Biến chứng viêm tai giữa
- Nguyên nhân mất thính lực ở trẻ
Cảm ơn bạn đã đọc bài - Chúc bạn ngày tốt lành!